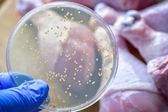
¡Atención! Reportan en México más de 4 mil casos de salmonelosis y tifoidea

La presidenta Claudia Sheinbaum Pardo conmemoró el Día Internacional de la Mujer el 8 de marzo, recibiendo el bastón de mando de mujeres indígenas en el Palacio Nacional. Durante la celebración, participó en un ritual indígena, acompañada por la jefa de Gobierno de la Ciudad de México, Clara Brugada, así como por otras funcionarias, incluida la secretaria de las Mujeres, Citlalli Hernández.
“Hoy las mujeres mexicanas estamos en la Constitución Política de los Estados Unidos Mexicanos”, destacó la mandataria.
Durante el ritual de purificación, mujeres indígenas apoyaron a Sheinbaum, agradeciéndole por su humildad y sabiduría. En su discurso, la Presidenta destacó la importancia histórica del evento, ya que se conmemoraba por primera vez bajo la presidencia de una mujer.
La presidenta anunció que a partir del 1 de agosto se comenzará a entregar pensiones a mujeres de 60 a 62 años, cumpliendo así el objetivo de apoyar a todas las mujeres de entre 60 y 64 años.
La presidenta anunció la creación de al menos 200 centros de educación y cuidado infantil para madres trabajadoras en todo el país, aunque no especificó cuándo estarán listos.
8 de marzo, Día Internacional de las Mujeres. Palacio Nacional https://t.co/gSX8XMmzyG
— Claudia Sheinbaum Pardo (@Claudiashein) March 8, 2025
Clara Brugada, junto a la Presidenta de México, destacó la relevancia de la ceremonia en la que tomaron parte por el Día Internacional de la Mujer.
“Este 8 de marzo es un día para la memoria histórica del país porque es la primera vez que lo encabeza una mujer presidenta, Claudia Sheinbaum, quien lidera las luchas por los derechos de todas las mujeres”.
La mandataria finalizó su discurso destacando un mensaje de inclusión, señalando que su ascenso a la presidencia representa a todas las mujeres mexicanas.
"No llegué sola, llegamos todas las mujeres mexicanas. ¡Vivan las mujeres indígenas de México! ¡Vivan las mujeres afrodescendientes! ¡Vivan las mujeres! ¡Viva México!."
&format=webp)
&format=webp)
&format=webp)